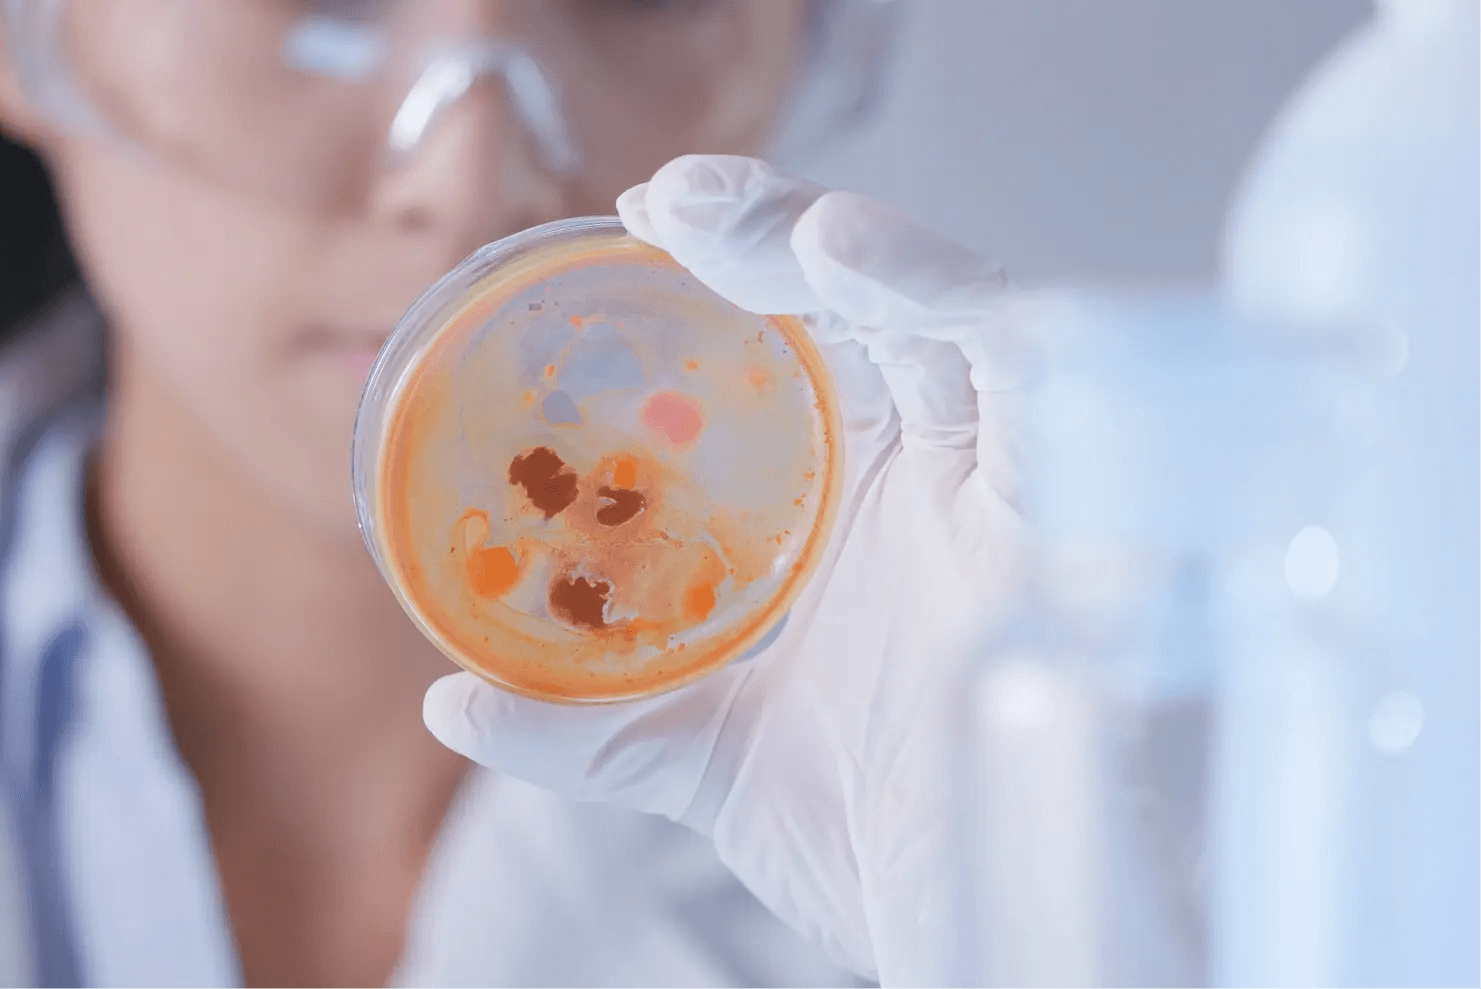

Katarzyna Jakubowska –
Koordynator POZ, rejestratorka medyczna, diagnosta laboratoryjny

Absolwentka Uniwersytetu Medycznego w Białymstoku
Poznaj mnie lepiej
Jestem absolwentką wydziału Farmaceutycznego z Oddziałem Diagnostyki Laboratoryjnej na kierunku Analityka Medyczna, gdzie uzyskałam tytuł magistra analityki medycznej.
Prywatnie uwielbiam podróże – te małe i te duże, a także spacery na świeżym powietrzu.

W czym mogę Ci pomóc?
Jestem koordynatorem POZ oraz wykonuje testy w diagnostyce Point Of Care (m.in. badania CRP, Strep-testy, testy antygenowe).
Poznaj opinie moich pacjentów
Paweł Z.
Polecam, profesjonalna obsługa, estetyczne wnętrza, aplikacja w której mam wgląd w swoje wizyty i recepty. Umówiona wizyta na daną godzinę, rzeczywiście miała miejce o tej godzinie, nie musiałem czekać w kolejce.
Agnieszka B.
Bardzo miła obsługa. Krotki czas oczekiwania w kolejce.
Mateusz H.
Super wiedza, punktualność i właściwie indywidualne podejście do każdego pacjenta. Nareszcie Boćki mają Przychodnie w której nie strach przechodzić przez żadną chorobę😁
Madzik
Bardzo polecam centrum medyczne ALMA MED w Boćkach. Personel był niesamowicie przyjazny i pomocny, co bardzo ułatwiło mi wizytę. Od samego początku czułam się dobrze zorientowana i w pełni poinformowana na temat mojego stanu zdrowia i procedur, które były mi oferowane. Pomieszczenia były czyste i schludne, a wyposażenie i sprzęt medyczny nowoczesny. Nie czekałam długo na moją wizytę. Poleciłabym go każdemu, kto szuka profesjonalnej opieki medycznej, w przyjaznej i wygodnej atmosferze.